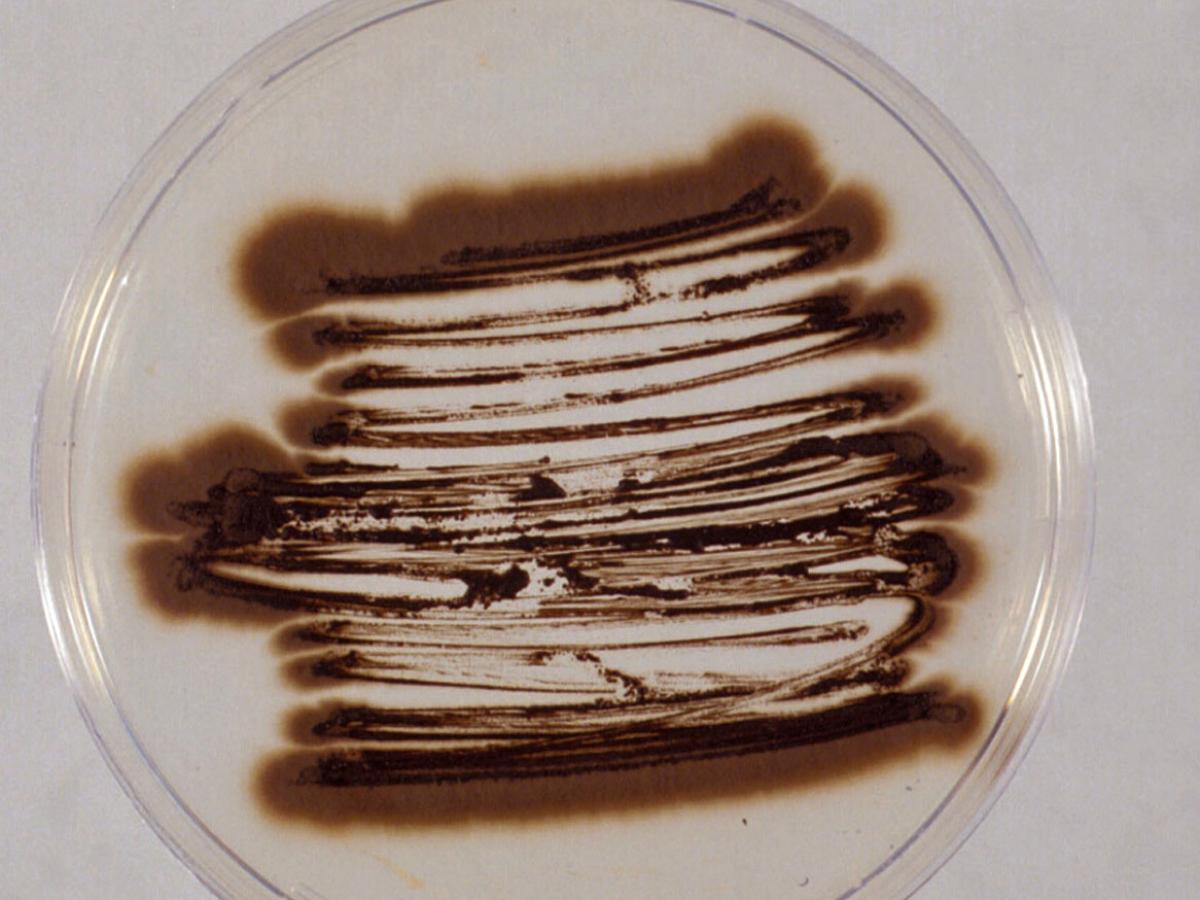
Culture

Status message
Correct! Excellent, you have really done well. Please find additional information below.
Unknown 16 = Exophiala jeanselmei
Direct microscopy (PAS stained tissue section): Brown pigmented (not seen in this PAS preparation), branching septate hyphae are typical of phaeohyphomycosis.

Culture: Colonies are initially smooth, greenish-grey to black, mucoid and yeast-like, becoming raised and developing tufts of aerial mycelium with age, often becoming dome-shaped and suede-like in texture. Reverse is olivaceous-black.
Microscopy: Yeast-like cells, torulose hyphae, conidiophores, annellides and conidia of E. jeanselmei.

Annellide and conidia of E. jeanselmei.

Comment: Exophiala species are common environmental fungi often associated with decaying wood and soil enriched with organic wastes. However, several species notably E. jeanselmei, E. moniliae and E. spinifera, are well documented human pathogens. Clinical manifestations include mycetoma (especially for E. jeanselmei), localized cutaneous infections, subcutaneous cysts, endocarditis and cerebral and disseminated infections. Phaeohyphomycosis caused by Exophiala species has been reported in both normal and immunosuppressed patients.
About Exophiala jeanselmei Back to virtual assessment